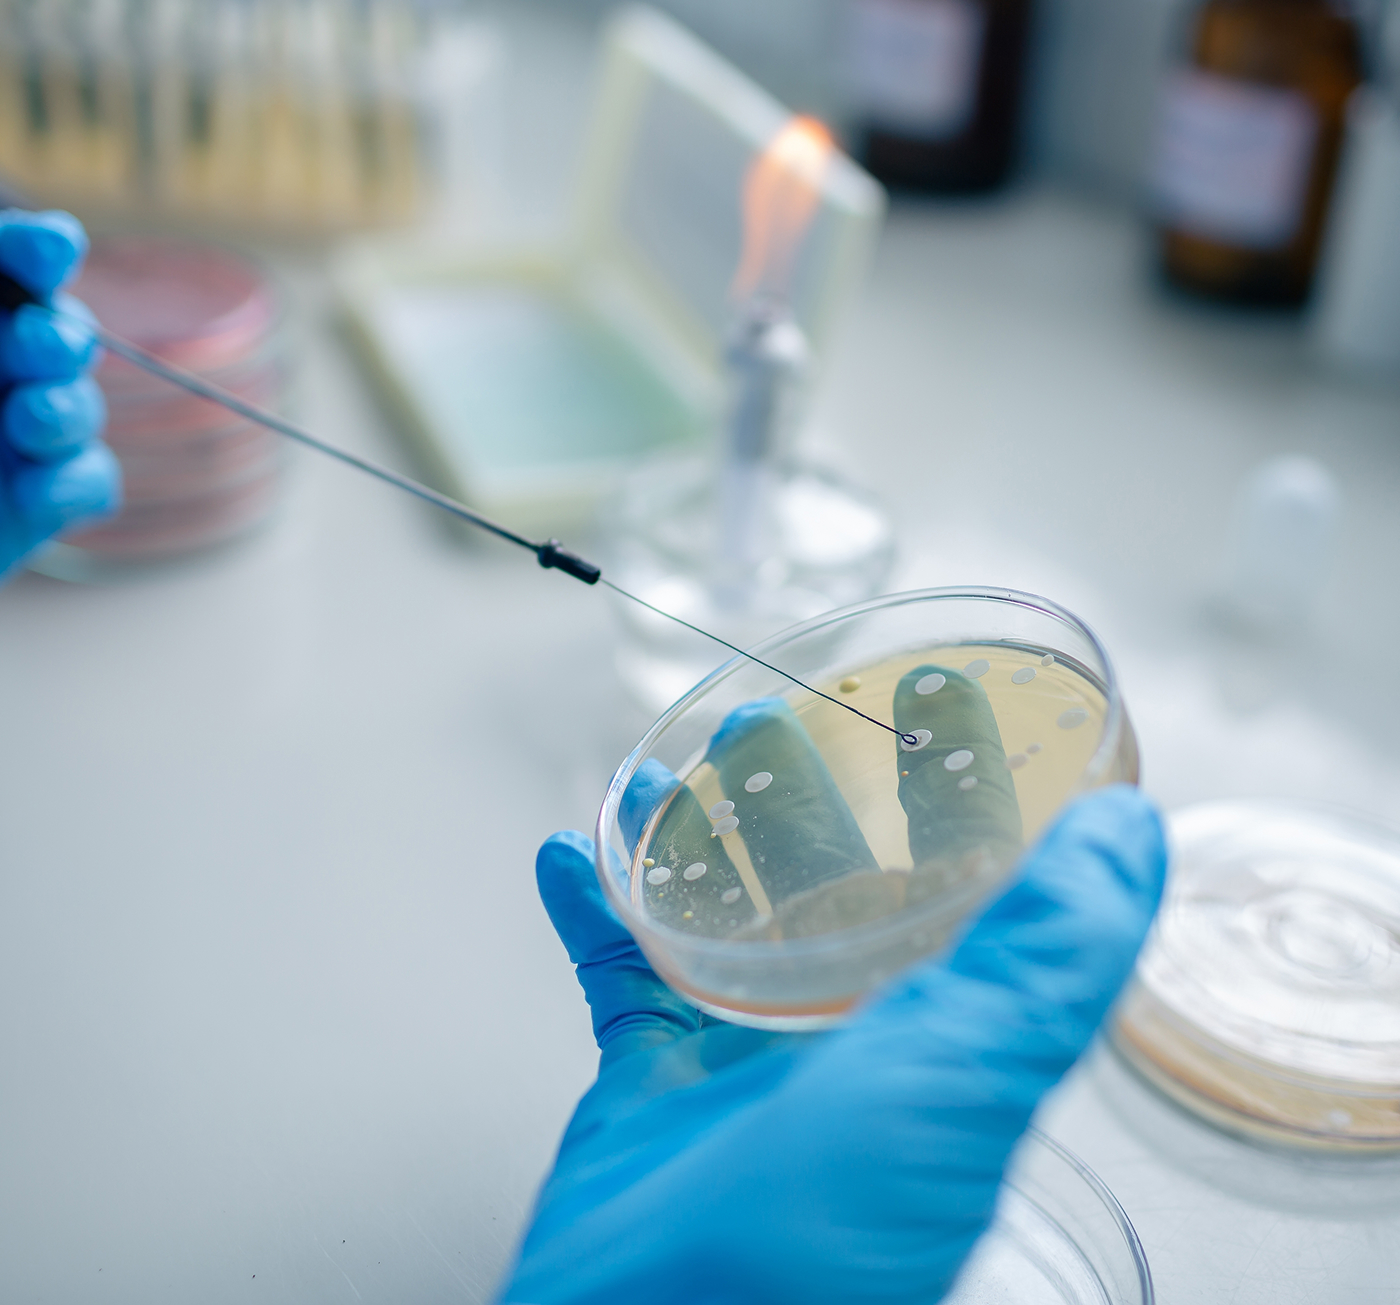

Nuestro Servicio
La especialidad de Infectología aborda la prevención, el estudio y el tratamiento de enfermedades infecciosas en pacientes adultos.
Se trabaja de manera articulada con otras áreas del sanatorio para asegurar una atención integral y basada en evidencia científica.
Servicios
- Evaluaciones clínicas especializadas: Diagnóstico y estudio detallado de patologías infecciosas.
- Seguimiento de infecciones: Manejo integral de cuadros tanto agudos como crónicos.
- Manejo de enfermedades transmisibles: Tratamiento específico enfocado en la recuperación y la salud pública.
- Asesoramiento en inmunizaciones: Orientación profesional sobre vacunas y esquemas de prevención.
Nuestras Sedes

Anexo A
Consultorios PAMI
Rivadavia 3083 / 0342 455 3255, Interno 3016 o 2029
Horario de Atención: Lun a Vie 8 a 20 hs
Nuestros Profesionales

Pedro Antonio Bertona
Infectólogo para adultos